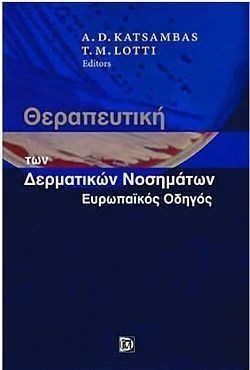
S��S� CU� ��

ΚΑΤΗΓΟΡΙΕΣ
NEWSLETTER
Συπληρώστε το email σας
για να λάβετε τις προσφορές
και τα νέα της Bookstation
ΝΕΟΙ ΤΙΤΛΟΙ
-
Νέος Κώδικας για Δημόσιες Συμβάσεις -11η έκδοση
Κωτσοβίνος Ευαγ. Βασίλης προσθήκη στο καλάθι
προσθήκη στο καλάθι
ISBN 978-618-84598-2-3
Τιμή | 54 € -
Πλήρης Οδηγός Φορολογιών Κατοχής Ακινήτων (Δήλωση Ε9/ΕΝΦΙΑ-Πιστοποιητικό/ΕΦΑ)
Αννα Κόλλια προσθήκη στο καλάθι
προσθήκη στο καλάθι
ISBN 978-618-83144-9-8
Τιμή | 54 € -
Οι κωδικοί του Ε9 (Δήλωση Ακινήτων)-2024 -ΑΜΕΣΑ ΔΙΑΘΕΣΙΜΟ
Ορέστης Εμμ. Σεϊμένης-Μανούσος Ιωάν. Ντουκάκης προσθήκη στο καλάθι
προσθήκη στο καλάθι
ISBN 978-618-87035-0-6
Τιμή | 54 €
περισσότερα >
Κατηγορίες / . / Ιατρική & υγεία / Ανθρωπολογία / Δερματολογία / Θεραπευτική των Δερματικών Νοσημάτων, Ευρωπαΐκός Οδηγός (2η έκδοση) (Αδετο)
Θεραπευτική των Δερματικών Νοσημάτων, Ευρωπαΐκός Οδηγός (2η έκδοση) (Αδετο)
A. KATSAMBAS - T. LOTTI
Εκδόσεις
Παρισιάνου Α.Ε.
ISBN: 978-960-394-335-8
Σελίδες: 990
Σχήμα: 17Χ24 cm
Εξώφυλλο: Χαρτόδετο
Ημερομηνία έκδοσης: 2005
Τιμή | 83 €
Πρόλογος Ελληνικής Έκδοσης
List of contributors xvii
Ακανθοκυτταρικό καρκίνωμα
D. Roseeuw και Α.Δ. Κατσάμπας
Ακμή ανάστροφη
R. Chatelain, C. Hary, B. Konz, και G. Plewig
Ακμή κοινή
W.J. Cunliffe, and D.C. Seukeran
Ακμή ροδόχρους
F. C. Powell
Ακτινική υπερκεράτωση
F. Camacho-Martinez
Αλωπεκία ανδρικού τύπου
C. Piιrard-Franchimont και G.E. Piιrard
Ανεμευλογιά
Σ. Γεωργαλά
Αντιφωσφολιπιδικό σύνδρομο
Π.Γ. Βλαχογιαννόπουλος και Χ. Μ. Μουτσόπουλος
Απεκκριτική ιδρώα
H. R. Bruckbauer και H. J. Vogt
Αποκρινής ιδρώα
H. R. Bruckbauer και H.J. Vogt
Ατοπική δερματίτιδα
E.J.M. Van Leent και J.D. Bos
Αφθώδης στοματίτιδα
Γ. Λάσκαρης
Βαλανίτιδα
D. Freedman
Βασικοκυτταρικό καρκίνωμα
D. Roseeuw και Α.Δ. Κατσάμπας
Γαγγραινώδες πυόδερμα
M. Camilleri και J.L. Pace
Γονοκοκκική ουρηθρίτιδα
D. Freedman
Γονόρροια
M. A. Waugh
Γυροειδής αλωπεκία
R. Happle
Δακτυλιοειδές κοκκίωμα
N. Raison-Peyron και J. Meynadier
Δασυτριχισμός
S. Rogers
Δερματική αγγειίτιδα
T. Ryan
Δερματίτιδα από επαφή
L. Kanerva
Δερματοπάθειες από το θαλάσσιο περιβάλλον
G. Monfrecola
Δερματοπάθειες από κρότωνες (τσιμπούρια)
G. Leigheb
Δερματίτιδα από σπάργανα
S. Reimann και T. A. Luger
Δερματίτιδα των χεριών
K. Thestrup-Pedersen
Δερματομυοσίτιδα
S. Jablonska
Δερματοφυτίες
A. Tosti και B. M. Piraccini
Δήγματα ακάρεων
G. Leigheb
Δοθιήνας και ψευδάνθρακας
R. Stadler και M. Westenberger-Treumann
Έλκη της κνήμης
A.A. Ramelet
Ερπητας απλός των γεννητικών οργάνων
P. Teofoli, P. Puddu και T. M. Lotti
Ερπητας απλός. Στοματο-προσωπική λοίμωξη
S. Kroon
Έρπητας ζωστήρας
Σ. Γεωργαλά
Ερπητοειδής δερματίτιδα.
C. Gooptu και F. Wojnarowska
Ερυθηματώδης λύκος
B. Crickx και S. Belaich
Ερυθρά ιόνθιος πιτυρίαση
W. A. D. Griffiths
Ερύθρασμα
Ε. Κουμαντάκη-Μαθιουδάκη
Ερυθροπλακία του Queyrat
B.-R. Balda
Ερυσίπελας
M. Balabanova
Ηλιακή κνίδωση
M. Jeanmougin
Θυλακίτιδα
G. R. Rousselet
Ιχθύαση
M. Paradisi και A. Giannetti
Κακόηθες μελάνωμα
B.R. Balda
Κακοήθης φακή
R.P.R. Dawber και Z.S. Gaspar
Καντιντίαση 309
Δ. Ρηγόπουλος
Κερατοακάνθωμα
P. Campolini, M. Benci, G. Vallecchi και Τ.Μ. Lotti
Κνησμός
Δ. Ιωαννίδης
Κνίδωση
F. Lawlor και M.Greaves
Λεϊσμανίαση
M. Φnder και M.A. Gόrer
Λεμφώματα πρωτοπαθή δερματικά
W. A. van Vloten
Λέπρα ή νόσος του Hansen
B. Flageul και L. Dubertret
Λεύκη
Α.Δ. Κατσάμπας, T.M. Lotti και J.P. Ortonne
Λιποειδική νεκροβίωση
Ε. Groshans
Λοίμωξη από HIV και AIDS:
Σημερινή κατάσταση της θεραπείας κατά των ρετροϊών
R. Husak, L. U. Wφlfer και K. E. Ορφανός
Μαστοκύτωση
A.P. Oranje και D. Van Gysel
Μέλασμα
Α. Δ. Κατσάμπας και T. M. Lotti
Μη γονοκοκκική ουρηθρίτιδα
D. Freedman
Μολυσματική τέρμινθος
M. V. Milinkovic και L.M. Medenica
Μολυσματικό κηρίο
S. Veraldi και R. Caputo
Morphea: εντοπισμένη σκληροδερμία
U.F. Haustein
Μυρμηκίες και κονδυλώματα
J.M. Mascars και J.M. Mascarσ Jr.
Νομισματοειδές έκζεμα
H. R. Bruckbauer, S. Karl και J. Ring
Νόσος Αδαμαντιάδη-Behηet.
C.C. Zouboulis
Νόσος του Bowen
Γ. Αυγερινού
Νόσος του Darier.
C. Varotti και F. Bardazzi
Ξανθώματα
A.D. Tosca και J.C. Katsantonis
Οζώδες ερύθημα
A. Claudy
Ομαλός λειχήνας
A. Rebora
Οξεία λειχηνοειδής πιτυρίαση
L. Andreassi
Ουλωτική αλωπεκία
A. Tosti και B. M. Piracini
Πέμφιγα βλαστική
Κ. Ε. Harman και M. M. Black
Πέμφιγα ερυθηματώδης
K. E. Harman και M. M. Black
Πέμφιγα κοινή
V. Ruocco και S. Brenner
Πέμφιγα φαρμακογενής
K. E. Harman και M. M. Black
Πέμφιγα φυλλώδης
K. E. Harman και M. M. Black
Ποικιλόχρους πιτυρίαση
M. Le Maξtre και A. Dompmartin
Πολύμορφο εξάνθημα εκ φωτός
J. Ferguson και A. D. Katsambas
Πολύμορφο ερύθημα
P. M. Brandao
Πομφολυγώδες πεμφιγοειδές
Α. Βαρελζίδης
Πομφολυγώδης επιδερμόλυση
G. Menchini, B. Bianchi και T. M. Lotti
Πορφύρες
Τ.Μ. Lotti, C. Comanchi, και I. Ghersetich
Πορφυρίες
M. Lecha και C. Herrero
Προκλητή δερματίτιδα
N. Tsankov και I. Stranski
Ροδόχρους πιτυρίαση
H. Degreef
Σαρκοείδωση
A. Rebora
Σάρκωμα Kaposi
Ι. Δ. Στρατηγός
Σμηγματορροϊκή δερματίτιδα
J. Faegermann
Σμηγματορροϊκή υπερκεράτωση
A. Picoto
Σπίλοι (καλοήθεις μελανοκυτταρικοί)
Ν. Γ. Σταυριανέας
Συγγενείς αγγειακοί σπίλοι: Αγγειακές διαμαρτίες
και αιμαγγειώματα
H. Yang και G.W. Cherry
Σύνδρομο Sjgren
Α.Γ. Τζιούφας και Χ.Μ. Μουτσόπουλος
Συστηματική σκληροδερμία
U.F. Haustein
Σύφιλη
M.A. Waugh
Τοξική επιδερμιδική νεκρόλυση
Α. Μηνάς
Υπεριδρωσία
G. Campanile, G. Hautmann και T. M. Lotti
Υποξύς δερματικός ερυθηματώδης λύκος
Μ.Ν. Μανουσάκης και Χ.Μ. Μουτσόπουλος
Φαινόμενο Raynaud
C. G. M. Kallenberg
Φαρμακευτικό εξάνθημα
J. Revus
Φθειρίαση
G. Campanile και G. Hautmann
Φωτογήρανση
N. M. Craven και C. E. M. Griffiths
Φωτοευαισθησία από φάρμακα
P. Santoianni και E. M. Procaccini
Χηλοειδή και υπερτροφικές ουλές
G. Hautmann και A. Mastrolorenzo
Χρόνια ακτινική δερματίτιδα
G. M. Murphy
Χρόνια λειχηνοειδής πιτυρίαση
G. Lange Vejlsgaard
Χρόνιος απλός λειχήνας
M. Gantcheva
Ψώρα
A. Gσrkiewicz-Petkow
Ψωρίαση
U. Mrowietz και E. Christophers
Απολέπιση με χημικά μέσα
I. Ghersetich, P. Teofoli, M. Ribuffo και T.M. Lotti
Απόξεση
E. Haneke
Βιοψία
E. Haneke
Εξωσωματική φωτοχημειοθεραπεία (φωτοφόρεση)
B.R. Balda
Επανορθωτική χειρουργική του τριχωτού της κεφαλής
S. Letessier
Επιδερμιδικές δοκιμασίες
Α. Κατσαρού
Επιφανειακή αναδιαμόρφωση δέρματος
με laser διοξειδίου του άνθρακα
S. Letessier και C. Vιrθs
Ηλεκτροχειρουργική
E. Haneke
Κρυοχειρουργική
M.C. Boullie και Ph. Lauret
laser στη δερματολογία
L. Leite
Μικροσκόπηση διά επιφωτοβολίας μελαγχρωματικών
δερματικών βλαβών
V. De Giorgi και P. Carli
Σκληροθεραπεία
E. Del Bianco, G. Muscarella και P. Cappugi
Στρατηγικές εμβολιασμού με δενδριτικά κύτταρα
για την αντιμετώπιση του κακοήθους μελανώματος
S. Moretti και T.M. Lotti
Τεχνικές αύξησης του δέρματος (εμφυτεύματα)
L. Rusciani και S. Petraglia
Φωτοθεραπεία με UVB ακτινοβολία
Χ. Αντωνίου
Φωτοχημειοθεραπεία
Χ. Αντωνίου
Χειρουργική του Mohs
A. Picoto, J.M. Labareda, R. Themido και F. Coehlo
Αντηλιακά
Δ. Ρηγόπουλος, Χ. Αντωνίου και Α.Δ. Κατσάμπας
Αντιβακτηριακοί παράγοντες στη δερματολογία
Ε. Γιαμαρέλλου
Αντιϊικά φάρμακα.
G. Hautmann, G. Campanile, E. Puma και Α.Δ. Κατσάμπας
Αντιϊσταμινικά
Α.Δ. Κατσάμπας, Α. Στρατηγός και T. M. Lotti
Αντιμυκητιασικά
V. Bettoli και A. Tosti
Αντιψωριακά και αντιφθειρικά φάρμακα
A. Gσrkiewicz-Petkow
Εντομοαπωθητικά
S. Motta και M. Monti
Λευκαντικοί παράγοντες
W. Westerhof και M.D. Njoo
Ρετινοειδή
J.H. Saurat
Συστηματικά γλυκοκορτικοειδή
J.G. Camarasa και A. Gimιnez-Arnau
Τοπικά αναισθητικά στη δερματολογία
E.B. de Waard-van der Spek και A.P.Oranje
Τοπικά κορτικοστεροειδή
J.G. Gamarasa και A. Gimιnez-Arnau
Τοπικά σκευάσματα και έκδοχα
M. Monti και S. Motta
Ψυχιατρικά φάρμακα στη δερματολογία
G. Hautmann και E. Panconesi
Άλλα βιβλία του συγγραφέα
ΑΝΑΖΗΤΗΣΗ
Σε όλες τις κατηγορίες
ΑΝΑΚΟΙΝΩΣΕΙΣ
9/5/2012 2:16:56 μμ
περισσότερα >
BEST SELLERS
-
Νέος Κώδικας για Δημόσιες Συμβάσεις -11η έκδοση
Κωτσοβίνος Ευαγ. Βασίλης προσθήκη στο καλάθι
προσθήκη στο καλάθι
ISBN 978-618-84598-2-3
Τιμή | 54 € -
Λατινικά ...για 20! (για τη Γ' Λυκείου)
Χρήστος Ζηκούλης προσθήκη στο καλάθι
προσθήκη στο καλάθι
ISBN 978-618-5837-00-6
Τιμή | 50 € -
Λατινικά...για 20! (Για τη Β' λυκείου)
Χρήστος Ζηκούλης προσθήκη στο καλάθι
προσθήκη στο καλάθι
ISBN 978-618-86835-9-4
Τιμή | 25 €
περισσότερα >


